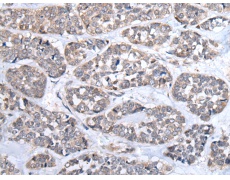
一抗

中文名稱:兔抗CD274多克隆抗體
英文名稱: Anti-CD274 rabbit polyclonal antibody
別 名: B7-H; B7H1; PDL1; PD-L1; PDCD1L1; PDCD1LG1
儲 存: 冷凍(-20℃)
宿 主: Rabbit
相關(guān)類別: 一抗
標 記 物: Unconjugate
克隆類型: rabbit polyclonal
技術(shù)規(guī)格
|
Background: |
This gene encodes an immune inhibitory receptor ligand that is expressed by hematopoietic and non-hematopoietic cells, such as T cells and B cells and various types of tumor cells. The encoded protein is a type I transmembrane protein that has immunoglobulin V-like and C-like domains. Interaction of this ligand with its receptor inhibits T-cell activation and cytokine production. During infection or inflammation of normal tissue, this interaction is important for preventing autoimmunity by maintaining homeostasis of the immune response. In tumor microenvironments, this interaction provides an immune escape for tumor cells through cytotoxic T-cell inactivation. Expression of this gene in tumor cells is considered to be prognostic in many types of human malignancies, including colon cancer and renal cell carcinoma. Alternative splicing results in multiple transcript variants. |
|
Applications: |
ELISA, WB, IHC |
|
Name of antibody: |
CD274 |
|
Immunogen: |
Synthetic peptide of human CD274 |
|
Full name: |
CD274 molecule |
|
Synonyms: |
B7-H; B7H1; PDL1; PD-L1; PDCD1L1; PDCD1LG1 |
|
SwissProt: |
Q9NZQ7 |
|
ELISA Recommended dilution: |
5000-10000 |
|
IHC positive control: |
Human esophagus cancer and Human liver cancer |
|
IHC Recommend dilution: |
40-200 |
|
WB Predicted band size: |
33 kDa |
|
WB Positive control: |
A549,Raji,RAW264.7,Jurkat and HepG2 cell lysates |
|
WB Recommended dilution: |
200-1000 |

 購物車
購物車 幫助
幫助
 021-54845833/15800441009
021-54845833/15800441009